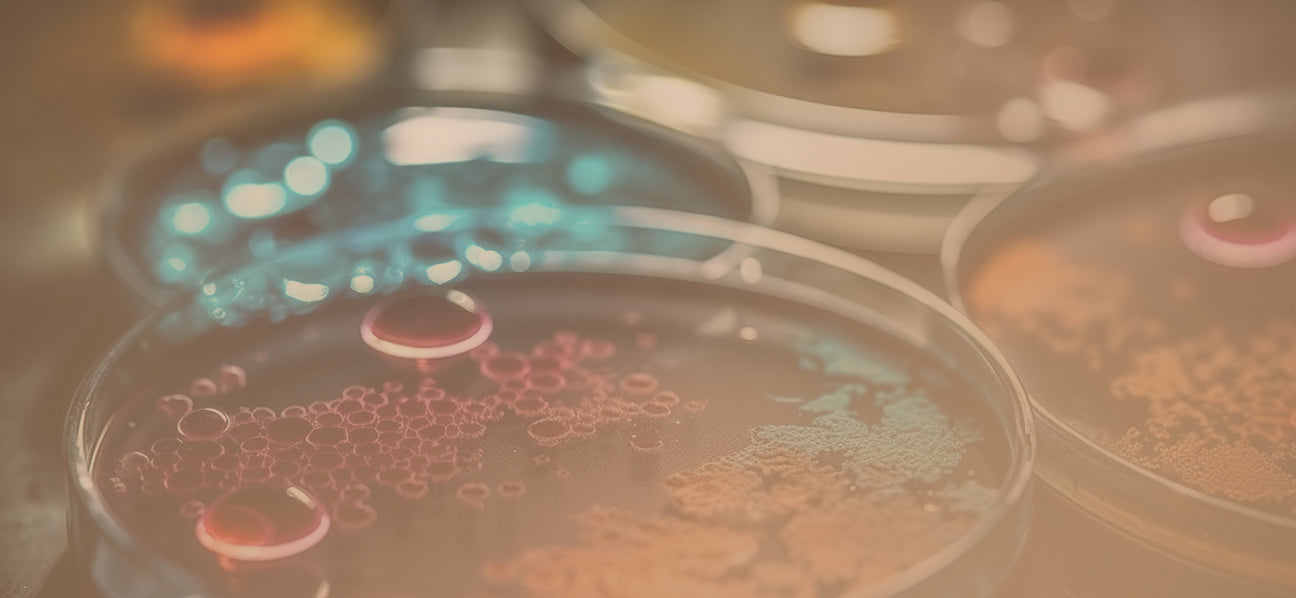

Methode
Über Xonigen
Xonigen ist ein daten- und wissenschaftsbasiertes Unternehmen mit Fokus auf Longevity (Langlebigkeit) und Epigenetik. Mit einem ganzheitlichen, präventionsorientierten Ansatz entwickelt Xonigen innovative
Gesundheitslösungen, die auf den neuesten Erkenntnissen aus Forschung und Wissenschaft basieren – darunter hochwertige Nahrungsergänzungsmittel sowie Bildungsangebote in den Bereichen Epigenetik, Präventivmedizin und Pflegewissenschaft.
Ziel unseres ganzheitlichen Ansatzes ist es, Menschen dabei zu unterstützen, ein längeres Leben bei guter Gesundheit und gesteigertem Wohlbefinden zu führen – und Wege aufzuzeigen, wie sich das aktiv und alltagstauglich umsetzen lässt. Unsere innovativen Produktlösungen basieren auf neuesten wissenschaftlichen Erkenntnissen aus der Epigenetik, der modernen Medizin und der Longevity-Forschung. Sie sind praxisnah konzipiert und lassen sich mühelos in den Alltag integrieren.
Die Xonigen Methode
Die Xonigen Methode basiert auf einer umfassenden Datenanalyse – wissenschaftlich fundiert, objektiv und
unabhängig von Interessenkonflikten. Wir analysieren fortlaufend eine Vielzahl von Studien, Forschungsergebnissen und Erfahrungswerten, um die effektivsten Strategien und Wirkstoffe zu identifizieren. Die Ergebnisse unserer Analysen fließen direkt in die Entwicklung unserer hochwertigen
Produktlösungen ein.
Unsere Produktlösungen beruhen auf wissenschaftlich geprüften, nachweislich wirksamen Substanzen und Methoden. Die hohe Qualität unserer Produkte wird durch unabhängige Labore und Experten
bestätigt. Wir sind überzeugt, dass die richtige Balance zwischen modernster Wissenschaft, persönlicher Anpassung und praxiserprobter Anwendung der Schlüssel zu echter Langlebigkeit und
nachhaltiger Gesundheit ist.
Unser ganzheitlicher Ansatz
Unser Ansatz ist ganzheitlich – denn Langlebigkeit und Gesundheit sind mehr als nur medizinische oder wissenschaftliche Fakten. Der menschliche Faktor spielt eine entscheidende Rolle: Selbst die beste Ernährung, Bewegung oder Supplementierung wirkt nicht, wenn Stress, Schlafmangel oder emotionale
Belastung den Körper aus dem Gleichgewicht bringen.
Deshalb setzt die Xonigen Methode nicht nur auf wissenschaftliche Präzision, sondern auch auf die Anpassung an die Lebensrealität unserer Kunden. Unsere Lösungen sind daher alltagstauglich konzipiert, leicht umzusetzen und langfristig praktikabel – denn echte Veränderung gelingt nur, wenn die Maßnahmen nachhaltig im Alltag integriert werden können.
Wir bleiben am Puls der Zeit
Die Wissenschaft im Bereich Longevity entwickelt sich rasant weiter – und wir bei Xonigen entwickeln uns
mit. Durch unser permanentes Monitoring der neuesten Forschungsergebnisse und wissenschaftlichen Erkenntnisse stellen wir sicher, dass unsere Produkte und Methoden stets auf dem aktuellen Stand der Wissenschaft sind.
Wir verfolgen zudem die spannenden Aktivitäten und Ansätze renommierter Persönlichkeiten im Bereich
Longevity. Einer der bekanntesten Experten ist Dr. David Sinclair, dessen Forschungsergebnisse und Theorien auch Gegenstand unserer Analysen sind. Ebenso verfolgen wir die Entwicklungen und Beiträge von führenden Experten wie Bryan Johnson, Dr. Peter Attia und vielen weiteren Pionieren der Longevity-Forschung und professionellen Anti-Ager.
Wir nutzen die wertvollen wissenschaftlichen Grundlagen, um unsere eigenen Strategien und Produkte
weiterzuentwickeln – immer mit dem Ziel, die effektivsten und praxistauglichsten Lösungen für ein längeres, gesünderes Leben zu bieten.
Longevity – Länger leben. Besser leben.
Longevity – also die Wissenschaft der Langlebigkeit – verfolgt das Ziel, ein längeres Leben bei gleichzeitig hoher Lebensqualität zu ermöglichen. Obwohl sie als Forschungsfeld in den letzten Jahren stark an Sichtbarkeit gewonnen hat, ist die Idee dahinter keineswegs neu: Der Wunsch nach einem gesunden, langen Leben begleitet die Menschheit seit jeher.
Was sich jedoch verändert hat, ist die wissenschaftliche Basis. Neue Erkenntnisse, insbesondere auf zellulärer und molekularer Ebene, lassen heute weitreichende Rückschlüsse auf die Ursachen des Alterns zu – und eröffnen Möglichkeiten, diesen Prozess gezielt zu beeinflussen.
Bereits jetzt deuten viele Studien und Innovationen darauf hin, dass sich die Lebenserwartung signifikant steigern lässt – und das bei verbesserter Gesundheit im Alter. Weltweit investieren Unternehmen und
Forschungseinrichtungen mit hohem Tempo in neue Verfahren und Technologien, die diese Entwicklung weiter vorantreiben. Was einst nach Science-Fiction klang, wird zunehmend wissenschaftliche Realität – vor allem durch Erkenntnisse zu den sogenannten Hallmarks of Aging, den zentralen biologischen Mechanismen des Alterns.
Epigenetik – Langlebigkeit beginnt auf zellulärer Ebene
Wahre Gesundheit entsteht dort, wo alles beginnt: auf zellulärer Ebene. Genau hier setzt die Epigenetik an – ein Forschungsfeld, das untersucht, wie die Aktivität unserer Gene durch Ernährung, Bewegung,
Stressmanagement und andere Lebensstilfaktoren beeinflusst werden kann, ohne die DNA-Struktur selbst zu verändern.
Die neuesten wissenschaftlichen Erkenntnisse zeigen, dass es möglich ist, gezielt darauf einzuwirken, welche
Gene in unserem Körper aktiv sind – und damit auch auf Prozesse, die das Altern verlangsamen oder beschleunigen können. Diese epigenetische Steuerung ist ein zentraler Schlüssel, um Gesundheit zu erhalten, das biologische Alter positiv zu beeinflussen und Langlebigkeit zu fördern.
Nahrungsergänzungsmittel mit innovativen Wirkstoffen, kombiniert mit gezielten Lebensstiloptimierungen,
können diesen Prozess aktiv unterstützen. Dieser tiefgreifende Zusammenhang zwischen Longevity und Epigenetik bildet den Leitgedanken unserer Produktentwicklung.
Die Xonigen Academy
Die Gründung der Xonigen Academy folgt der Philosophie von Xonigen, Bildung als Brücke zwischen wissenschaftlichem Fortschritt und praktischer Anwendung zu verstehen. Wissen ist die Grundlage jeder nachhaltigen Veränderung. Deshalb machen wir unsere wissenschaftliche Expertise nicht nur in
Form hochwertiger Produkte zugänglich, sondern auch durch die Xonigen Academy – unsere Plattform für fundierte Weiterbildung in den Bereichen Epigenetik, Präventivmedizin und Pflegewissenschaft.
Die Academy vereint theoretisches Wissen mit praxisorientierten Methoden – damit neue wissenschaftliche Erkenntnisse nicht nur verstanden, sondern auch direkt in den Alltag integriert werden können. Dabei entsteht ein dynamischer Kreislauf: Erkenntnisse aus der Produktentwicklung und datenbasierten Analyse fließen in unsere Bildungsinhalte ein – umgekehrt liefert die praktische Erfahrung aus den Weiterbildungen wertvolle Impulse für die kontinuierliche Verbesserung unserer Lösungen.
Die Xonigen Academy ist damit mehr als nur eine Ergänzung – sie ist ein zentraler Bestandteil unseres ganzheitlichen Ansatzes für gesunde Langlebigkeit.
Produktqualität und Sicherheit
Bei Xonigen steht Qualität an erster Stelle. Alle in unseren Produkten eingesetzten Rohstoffe sind von hoher Reinheit und Qualität, werden sorgfältig verarbeitet und unterliegen einer kontinuierlichen Kontrolle. Die Zusammensetzung und Qualität unserer Produkte lassen wir regelmäßig von unabhängigen Laboren
prüfen – insbesondere mit Blick auf Reinheit, korrekte Deklaration und den Ausschluss möglicher Schadstoffe.
Auch in der Produktentwicklung folgen wir einer klaren Linie: Unsere Rezepturen basieren auf aktuellen wissenschaftlichen Erkenntnissen und orientieren sich konsequent an den empfohlenen Höchstmengen für die tägliche Aufnahme, wie sie von nationalen und europäischen Behörden definiert sind – stets in einem
ausgewogenen Verhältnis zwischen Wirkung und Sicherheit.
Dabei streben wir stets ein optimales Verhältnis zwischen Dosierung, Wirkung, Sicherheit, regulatorischer Konformität und Wirtschaftlichkeit an – mit dem Ziel, wirksame und vertrauenswürdige Produkte zu schaffen.